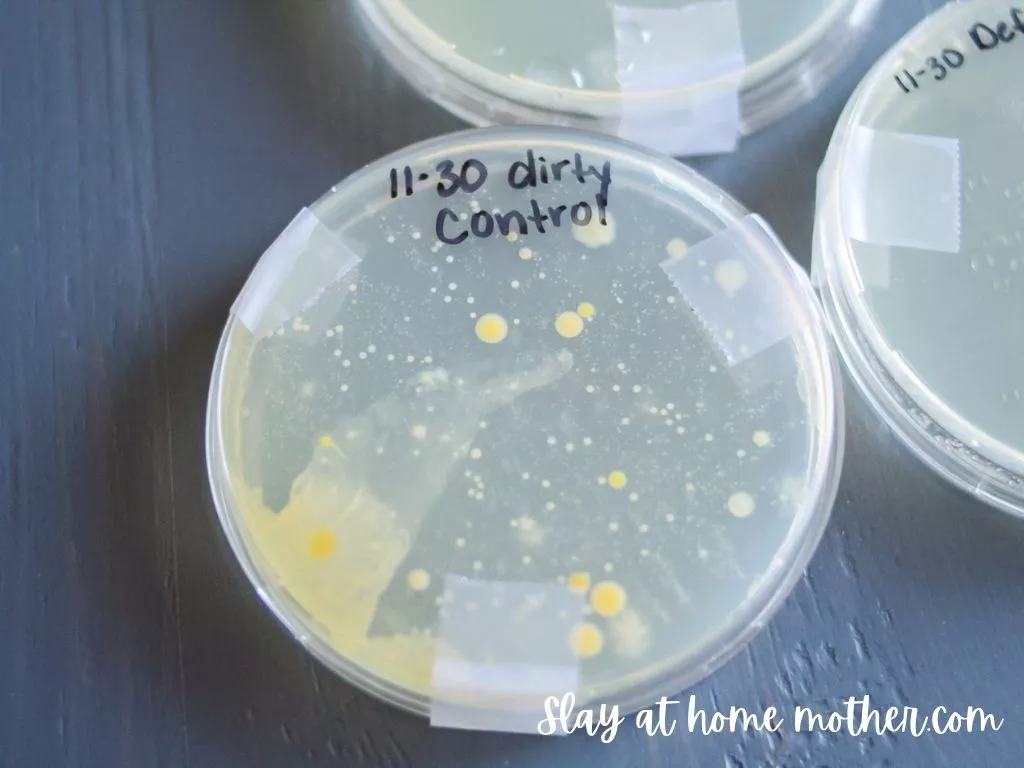

Make your own Natural Disinfectant Spray to take with you when you’re on-the-go…

Hey there, clean freaks!
I’m so excited about this post – it’s been in the works for over a week now and I can’t wait any longer to share it with you.
I’ve been growing bacteria…
Yep. You read that right.
I’ve been testing out some cleaners, swabbing dirty and clean surfaces, incubating for several days, and recording my results.
In part of all that research (to be published soon!), I’ve incorporated some essential oils.
And I figured out how to make my own DIY essential oil disinfectant spray!
I tried this mixture out a few weeks ago during a huge agar plates period I was going through (and am still obsessed with) on Instagram where I swabbed dirty surfaces in our home before and after cleaning.
The results wowed me and shocked me.
If I wasn’t an essential oil believer then, I am now!
In this post, I’ll be sharing my experiment with you, the results, as well as how to make your own natural disinfectant spray.
*This post is non-sponsored, and contains affiliate links, however, all opinions are my own, as always.
General Safety Information Regarding Homemade Cleaners
This natural disinfectant spray is made with essential oils, which have not been approved by the FDA or EPA to claim to kill bacteria, viruses, pathogens, etc.
Here is a list of approved disinfectants that you should use in your home for that purpose.
This homemade disinfectant spray has not been proven to kill a certain percentage or type of bacteria.
I am also not a scientist nor a microbiologist.
The information within this blog post is accurate to the best of my ability and knowledge, although without scientific backing.
This natural disinfectant spray has not been tested for safety or effectiveness, and the Petri dishes shown in this post do not substitute any official testing or ruling completed by the FDA at the time of this writing or in the future.
I am only sharing my experience and at-home test results with you.
Simply Earth, the company whose oils I am featuring in this post, is not sponsoring or asking me to write this post and has made no claim on its cleaning or disinfecting efficacy against germs or bacteria.
Before You See The Petri Dish Pictures…
In these Petri dishes, you’ll see water droplets.
This is condensation and is completely normal as the dishes are incubated.
My particular agar plates require incubation upside down, where the lid is against a flat surface and the actual plate with agar in it is facing UP.
If you are doing this test at home, be sure to follow the instructions included with your plates for the most accurate results.
I liked being able to incubate them upside down, though, because the condensation rested in the lid versus in the plate along with the bacteria.
Here are the agar plates I purchased and used (I have bought several orders of these and they have always been clean, uncontaminated, and in great condition).
And the sterile swabs I purchased separately.
I used a new bottle of water to moisten my cotton tip wood applicator before swabbing each surface, and a new swab per sample.
TESTING MY NATURAL DISINFECTANT SPRAY IN AGAR PLATES
To start, I took a fresh agar plate and secured the lid with tape – never opening it. This was my CLEAN CONTROL plate.
This ensures that my plates are not contaminated. If this plate happened to grow bacteria during incubation without ever being opened, I would know that it was at one point contaminated and I would need to repeat the experiment with new agar plates.
I then swabbed the surface of our spare bathroom counters before cleaning and labeled it DIRTY CONTROL.
This plate is important because it ensures that the surface was dirty before I applied any cleaner. it’s also a great comparison to use to see how well a cleaner or disinfectant works against the bacteria on that surface.
For the final plate, I mixed up some homemade essential oil disinfectant spray (see the recipe below), sprayed my bathroom counters 6-7x to ensure I fully coated the surface, waited about 30 seconds, and wiped them with a paper towel.
All three plates were incubated together for three days – these are the results:

The DIRTY CONTROL plate grew some pretty nasty stuff!
It makes my skin crawl…

The CLEAN CONTROL plate looks perfectly clear – no colonies are present, which ensures me that the plates I’m using were indeed clean and not contaminated – yay!

And here’s a side-by-side comparison of how my homemade disinfectant spray held up against the bacteria on our bathroom counters…

It worked amazingly!
There’s some condensation that you can see (water droplets) from the plates being incubated, but no bacteria.

I’m so impressed with how well this spray worked.
Natural Disinfectant Experiment Conclusions
When it comes to essential oils, I love running different blends in my diffuser and making new things with essential oils.
I’ve read a lot about different essential oil cleaners, sprays, and disinfectants – but are they legit?
Do they really disinfect?
I’ll be honest – I wasn’t expecting these results to prove anything.
I was more interested to see how dirty my counters were (and boy, was this a great motivator for cleaning them more often!), and if the essential oil sprays would reduce the bacteria at all.
But…*no* colonies?!
No bacterial growth??
I’m just blown away.
I think this experiment shows that essential oils CAN kill bacteria.
So, What is Defender oil?
Defender oil is Simply Earth’s blend that is comparable to thieves essential oil (by Young Living).
I found Simply Earth last year and I’m so glad that I did – they’re an incredible essential oil brand that believes in providing 100% pure, 3rd-party GC/MS tested oils while charging a fair price.
They also donate 13% of their profits to fight human trafficking.
Here are some Simply Earth subscription box features I’ve recently published:
Simply Earth December Box – An Essential Oil Recipes Subscription
Simply Earth Essential Oils November 2020 Recipe Box
Simply Earth October Box + A GIVEAWAY!
Simply Earth Essential Oils Subscription Box Review 2020
What You Need TO Make DIY Essential Oil Disinfectant

To make this DIY disinfectant spray, here’s what you need:
- 2 oz. distilled water
- 1 tsp. witch hazel
- 15 drops Defender essential oil blend
- 1 2 oz. amber glass spray bottle
For the water in this recipe, I wanted to note that while I listed distilled water, you can also use purified water.
To make this natural disinfectant spray, combine 1 tsp. witch hazel and 15 drops of Simply Earth’s Defender oil blend in your glass bottle.
Add in 2 oz. of distilled water (fill your glass bottle up to the top), and shake to combine.

Use as you see fit!


You could spray this on a number of different surfaces, such as:
- countertops
- baby toys (wipe down with a wet washcloth after)
- doorknobs and handles
- sinks
- toilets
- stair rails
- light switches
- faucets
- old shoes
- stinky backpacks
- garbage cans
- highchairs (wipe down with a wet washcloth after)
- tables
- remotes


This makes a great on-the-go natural disinfectant spray that can easily fit in your diaper bag, and can tackle nasty germs!
Don’t forget that you can also diffuse Defender essential oil to help boost your immunity.
Safety Information For Defender Oil

Defender oil from Simply Earth is kid-safe ages 10+.
Don’t worry about trying to remember this, though, as each Simply Earth bottle has safety information printed on the side!
It is not recommended for pregnant or breastfeeding moms.
For more information regarding the Defender essential oil blend, visit the safety information page.
I hope you enjoyed this post and feel confident making your own natural disinfecting spray at home – especially when stores seem to be running out right now.
Here are some other natural cleaning posts for you:
Force Of Nature Review: Cleaning With Hypochlorous Acid
Cleaning With Ozonated Water – Does It Really Work?
Simply Earth Subscription Box Review And Unboxing
*Post originally published December 2020, last updated January 2022.
